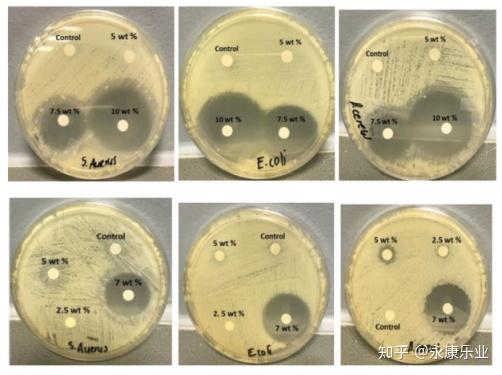
2024年量子点膜行业发展现状、竞争格局及未来发展趋势分析_人保服务 ,人保服务

2024年量子点膜行业发展现状、竞争格局及未来发展趋势分析
- 量子点膜行业发展机遇大,如何驱动行业内在发展动力?
-


图片来源于网络,如有侵权,请联系删除
免费提问专家- 北京用户提问:市场竞争激烈,外来强手加大布局,国内主题公园如何突围?
- 上海用户提问:智能船舶发展行动计划发布,船舶制造企业的机
- 江苏用户提问:研发水平落后,低端产品比例大,医药企业如何实现转型?
- 广东用户提问:中国海洋经济走出去的新路径在哪?该如何去制定长远规划?
- 福建用户提问:5G牌照发放,产业加快布局,通信设备企业的投资机会在哪里?
- 四川用户提问:行业集中度不断提高,云计算企业如何准确把握行业投资机会?
- 河南用户提问:节能环保资金缺乏,企业承受能力有限,电力企业如何突破瓶颈?
- 浙江用户提问:细分领域差异化突出,互联网金融企业如何把握最佳机遇?
- 湖北用户提问:汽车工业转型,能源结构调整,新能源汽车发展机遇在哪里?
- 江西用户提问:稀土行业发展现状如何,怎么推动稀土产业高质量发展?
量子点膜是以量子点为核心功能材料的高科技薄膜,其核心原理基于量子点的量子限域效应。当量子点尺寸小于激子玻尔半径时,其电子能级由连续态转变为分立态,通过调控量子点粒径可实现发光波长的精确控制。这种特性使量子点膜能够将蓝光高效转换为红光和绿光,形成全光谱覆盖,显著提升显示设备的色域、对比度和能效。相较于传统荧光粉和OLED材料,量子点膜具有色纯度高、寿命长、制造成本低等优势,成为LCD背光升级和新型显示技术发展的重要方向。
图片来源于网络,如有侵权,请联系删除
一、量子点膜行业发展现状分析

图片来源于网络,如有侵权,请联系删除
技术发展路径
根据中研普华研究院撰写的《2024-2029年中国量子点膜行业深度调研及发展前景预测报告》显示,量子点膜的技术演进经历三个阶段:初期以量子点管形式应用于高端电视背光,通过玻璃管封装实现光色转换;中期发展为量子点膜,采用PET基材与高阻隔膜复合工艺,提升材料稳定性和加工灵活性;当前正探索量子点扩散板技术,将量子点直接分散于扩散板基材中,进一步简化背光结构。技术突破点集中在无镉量子点开发、柔性基材适配和长寿命封装工艺,其中钙钛矿量子点因高量子产率和可溶液加工特性,成为下一代技术焦点。
应用领域拓展
显示领域是量子点膜的主要应用市场,覆盖电视、显示器、笔记本电脑、手机等消费电子产品。在电视市场,量子点技术已成为高端产品的标配,通过提升色域至BT.2020标准的90%以上,满足4K/8K超高清显示需求。在显示器领域,图形设计、影视后期等专业用户对色彩精准度的要求,推动量子点膜在专业显示市场的渗透率持续提升。手机领域,量子点膜与OLED柔性屏的结合,为折叠屏手机提供高色域、低功耗的显示解决方案。
非显示领域的应用探索取得突破。在照明领域,量子点膜与LED结合实现高显色指数(CRI>90)和可调色温,应用于商业照明和健康照明市场。生物医疗领域,量子点膜作为荧光标记材料,用于肿瘤成像和药物递送系统,其生物相容性和光稳定性优于传统有机染料。光伏领域,量子点膜作为光吸收层,通过多激子生成效应提升太阳能电池转换效率,钙钛矿量子点电池的实验室效率已突破18%。
产业链结构
量子点膜产业链包括上游原材料、中游制造和下游应用三个环节。上游原材料中,量子点粉体是核心,其合成工艺(如热注入法、微波辅助法)直接影响发光效率和稳定性;高阻隔膜用于防止水氧侵蚀,是保障量子点寿命的关键;UV胶水用于层间复合,需满足透光率高、收缩率低等要求。中游制造环节,涂布工艺决定量子点层的均匀性,模切工艺影响产品良率,精密涂布机和激光模切设备成为制造瓶颈。下游应用市场呈现多元化特征,显示设备制造商占据主导地位,照明、生物医疗等新兴市场处于培育期。
二、量子点膜行业竞争格局分析
市场参与者类型
量子点膜市场呈现“国际巨头主导、国内企业崛起”的竞争格局。国际企业如Nanosys、Quantum Materials Corp在量子点粉体合成领域占据技术制高点,其产品性能稳定、专利布局完善,但制造成本较高。国内企业如TCL集团、激智科技通过垂直整合策略,构建从量子点合成到膜片制造的全产业链能力,在成本控制和快速响应市场方面具有优势。初创企业如致晶科技聚焦钙钛矿量子点技术,通过差异化创新切入细分市场。
竞争维度分析
技术竞争聚焦于量子点性能提升和工艺优化。无镉化是重要方向,国内企业通过掺杂技术实现镉含量低于100ppm,满足RoHS法规要求;柔性基材适配方面,PI(聚酰亚胺)基膜的耐高温特性使其成为折叠屏首选,但成本较PET基材高3-5倍;封装工艺创新中,原子层沉积(ALD)技术可形成致密氧化铝层,将量子点寿命延长至5万小时以上。
成本竞争驱动产业链协同降本。上游原材料国产化率提升是关键,国内企业已实现高阻隔膜和UV胶水的自主供应,量子点粉体进口依赖度从80%降至50%;中游制造环节,卷对卷(R2R)涂布技术实现连续化生产,单线产能提升3倍,单位成本下降40%;下游应用市场,通过“量子点膜+Mini LED”的混合背光方案,在提升显示效果的同时控制成本,推动量子点技术向中端市场渗透。
市场拓展竞争体现为应用场景创新。显示领域,企业与面板厂商合作开发量子点-OLED(QD-OLED)和量子点-Micro LED(QD-Micro LED)技术,抢占下一代显示技术制高点;非显示领域,与照明企业联合开发量子点灯具,与生物医药公司合作研发荧光探针,拓展市场边界。
三、量子点膜行业未来发展趋势分析
技术创新趋势
量子点材料创新将推动性能跃升。钙钛矿量子点通过离子交换法实现粒径精准控制,发光效率较传统CdSe量子点提升50%;核壳结构量子点通过界面工程抑制非辐射复合,量子产率突破95%;量子点图案化技术通过光刻工艺实现像素级定位,为Micro LED显示提供解决方案。
制造工艺创新将提升产业竞争力。喷墨打印技术实现量子点膜的溶液法制造,材料利用率从30%提升至90%,设备投资成本降低60%;卷对卷(R2R)封装技术结合柔性基材,支持量子点膜的曲面和可折叠应用;人工智能在工艺优化中的应用,通过机器学习模型预测涂布参数,将产品良率从85%提升至95%。
市场应用趋势
显示市场将持续主导需求。超高清视频产业发展行动计划推动8K电视渗透率提升,量子点膜作为实现BT.2020色域的关键材料,需求量将保持高速增长;车载显示市场,量子点膜的高亮度和宽温工作特性满足智能座舱需求,预计2025年车载量子点显示器市场规模将突破10亿美元;VR/AR市场,量子点膜与Fast LCD结合,解决纱窗效应和色彩不足问题,推动消费级VR设备普及。
非显示市场将迎来爆发期。照明领域,量子点灯具在商业照明市场的渗透率预计2025年达到20%,在健康照明市场(如 circadian rhythm调节)的应用处于起步阶段;生物医疗领域,量子点膜用于体外诊断试剂盒,市场规模预计2025年突破5亿美元;光伏领域,量子点薄膜作为叠层电池的中间层,可提升电池效率2-3个百分点,技术成熟后将重塑光伏产业格局。
产业生态趋势
产业链协同将深化。上游原材料企业与中游制造商建立联合实验室,共同开发定制化材料;中游企业与下游应用厂商实施“技术共研+产能共建”模式,缩短产品开发周期;面板厂商与品牌商合作推广量子点显示标准,构建产业生态壁垒。
国际化竞争将加剧。国内企业通过海外建厂(如TCL在越南、印度布局量子点膜生产线)和并购(如激智科技收购韩国量子点材料企业)拓展国际市场;国际企业加大在中国市场的研发和制造投入,Nanosys在上海设立研发中心,聚焦无镉量子点技术开发。
政策支持将加强。国家层面将量子点技术纳入“十四五”新材料发展规划,通过重大专项支持基础研究;地方政府出台税收优惠和补贴政策,鼓励量子点膜在超高清视频、新能源汽车等领域的示范应用;标准制定方面,全国半导体设备和材料标准化技术委员会牵头制定量子点膜行业标准,规范市场秩序。
欲了解量子点膜行业深度分析,请点击查看中研普华产业研究院发布的《2024-2029年中国量子点膜行业深度调研及发展前景预测报告》。
2024-2029年中国量子点膜行业深度调研及发展前景预测报告
量子点膜,也称为Q膜,是一种先进的高科技材料,主要用于显示技术领域。量子点膜的核心成分是量子点,这是一种尺寸在1-10nm之间的纳米材料。量子点具有独特的光电性质,当受到外部光子的能量激L...
查看详情 →
- 中国量子点膜行业:2025掌握光的密码,定义显示未来
- 2025量子点膜市场规模 量子点膜行业发展现状前景研究
- 量子点膜行业发展趋势及政策分析
- 引领科技的前沿新型材料——量子点膜市场需求分析、未来趋势预测
- 2024年量子点膜行业供需分析及前景预测
-
让决策更稳健 让投资更安全
-
掌握市场情报,就掌握主动权,扫码关注公众号,获取更多价值:
3000+ 细分行业研究报告 500+ 专家研究员决策智囊库 1000000+ 行业数据洞察市场 365+ 全球热点每日决策内参
-

中研普华
-

研究院
玩具行业现状与发展趋势分析
玩具行业现状与发展趋势分析玩具行业作为全球消费市场的重要组成部分,近年来正经历着深刻的变革。随着科技的不断进步和消费者需求的多样化...
2025年中国信息安全行业:合规与实战双驱动下的千亿级新蓝海
2025年中国信息安全行业:合规与实战双驱动下的千亿级新蓝海前言在数字化转型加速与全球网络攻击复杂化的双重驱动下,信息安全已从技术辅助...
2025年中国铝合金行业:低空经济与5G基站散热革命催生细分赛道红利
2025年中国铝合金行业:低空经济与5G基站散热革命催生细分赛道红利前言在全球制造业向绿色低碳转型的背景下,铝合金凭借轻量化、高强度及可...
2025-2030年中国浓缩饲料行业投资策略与风险规避
2025-2030年中国浓缩饲料行业投资策略与风险规避前言浓缩饲料作为畜牧业的重要投入品,其发展水平直接关系到养殖效率与肉品质量。2025-2030...
乘用车行业现状与发展趋势分析
乘用车行业现状与发展趋势分析一、行业现状:技术跃迁与市场重构的双重变革(一)技术架构从电动化向智能化深度演进当前乘用车行业正经历从...
2025-2030医药行业趋势前瞻:创新药黄金时代与中医药现代化突围
2025-2030医药行业趋势前瞻:创新药黄金时代与中医药现代化突围前言医药行业作为国民经济的重要组成部分,是保障人民健康、推动社会进步的2...
随身WiFi设备行业发展现状分析与未来展望
2025LED屏幕行业市场规模及产销需求、未来趋势分析
2025年电讯产品行业发展现状深度调研及未来趋势展望分析
2025年中国插头插座行业市场竞争格局分析及发展前景预测,全新的增量市场
2025年功率器件行业发展现状分析及市场前景预测
